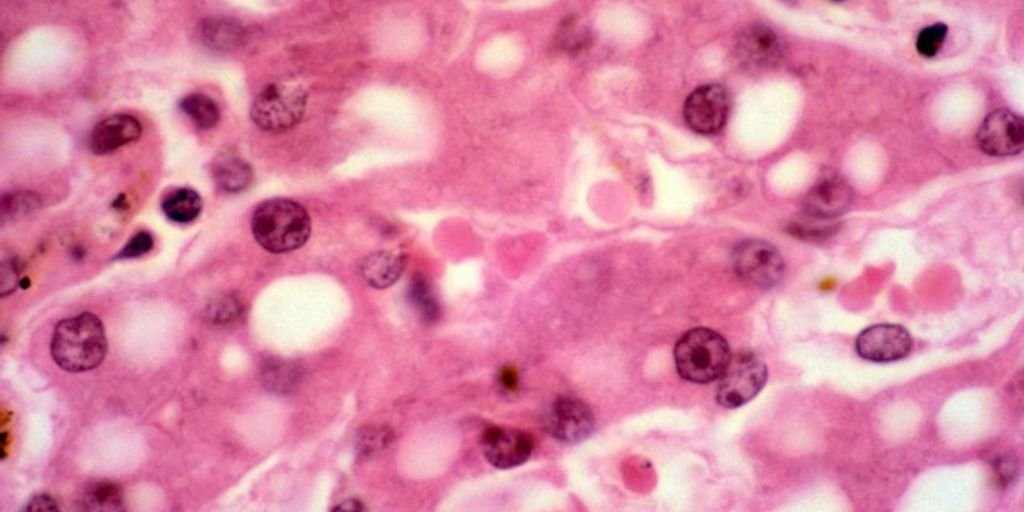
liver health supplement

In today’s fast-paced world, keeping your liver healthy is more important than ever. Elements Liv A Gain is a supplement that promises to support liver function through a mix of natural ingredients. This article will dive deep into how Elements Liv A Gain works, its benefits, and how you can include it in your daily routine for better liver health.
Key Takeaways
- Elements Liv A Gain is designed to support liver health with natural ingredients.
- The supplement provides important antioxidants that help protect the liver.
- Scientific research backs the effectiveness of Elements Liv A Gain.
- User testimonials highlight positive experiences with the supplement.
- It’s important to buy from authorized sellers to avoid counterfeit products.
Understanding Elements Liv A Gain
Elements Liv A Gain is a supplement designed to support liver health. It contains a unique blend of herbs known in Ayurveda for treating liver problems like sluggish liver, infected liver, and fatty liver. This tonic aims to improve liver function and overall well-being.
Key Ingredients and Their Roles
The key ingredients in Elements Liv A Gain include milk thistle, dandelion root, and turmeric. Each of these herbs plays a vital role in promoting liver health. Milk thistle is known for its ability to protect liver cells from damage. Dandelion root helps in detoxifying the liver, while turmeric has anti-inflammatory properties that support liver function.
How It Supports Liver Function
Elements Liv A Gain supports liver function by enhancing the liver’s natural detoxification process. The herbs in the tonic work together to remove toxins from the liver, improve digestion, and boost overall liver health. This combination of herbs makes Elements Liv A Gain a powerful tool for maintaining a healthy liver.
Scientific Research and Findings
Scientific research has shown that the ingredients in Elements Liv A Gain are effective in supporting liver health. Studies have demonstrated that milk thistle can help regenerate liver cells, while dandelion root and turmeric have been found to reduce inflammation and support liver detoxification. These findings highlight the potential benefits of using Elements Liv A Gain for liver health.
Elements Liv A Gain offers a natural and effective way to support liver health, making it a valuable addition to your wellness routine.
The Role of Antioxidants in Liver Health
Importance of Antioxidants
Antioxidants are crucial for maintaining liver health. They help protect liver cells from damage caused by free radicals. Free radicals can harm cells and lead to various diseases. By neutralizing these harmful molecules, antioxidants play a key role in keeping the liver functioning well.
How Elements Liv A Gain Provides Antioxidants
Elements Liv A Gain is rich in antioxidants that support liver health. The supplement contains natural ingredients known for their antioxidant properties. These ingredients help in reducing oxidative stress and promoting overall liver function.
Comparing Antioxidant Sources
When comparing antioxidant sources, it’s important to consider their effectiveness and availability. Elements Liv A Gain offers a convenient and potent source of antioxidants. Unlike some other supplements, it combines multiple antioxidant-rich ingredients in one formula, making it easier to incorporate into your daily routine.
Antioxidants are essential for protecting the liver from damage and ensuring its proper function.
Detoxification and Elements Liv A Gain
Natural Detoxification Process
The liver is a vital organ that helps remove toxins from the body. It works hard to filter out harmful substances and keep us healthy. Elements Liv A Gain supports this natural detox process, making it easier for the liver to do its job. The supplement contains natural ingredients that help improve liver function and promote overall well-being.
Enhancing Detox with Elements Liv A Gain
Using Elements Liv A Gain can enhance the body’s detoxification process. The supplement is designed to support liver health and improve digestion. By promoting better liver function, it helps the body get rid of toxins more effectively. This can lead to better health and more energy.
User Experiences and Testimonials
Many users have shared positive experiences with Elements Liv A Gain. They report feeling healthier and having more energy. Some users also mention improved digestion and better overall health. These testimonials highlight the benefits of using Elements Liv A Gain for liver support and detoxification.
Elements Liv A Gain is a great choice for anyone looking to support their liver health and improve their overall well-being.
Comparing Elements Liv A Gain with Other Supplements
Unique Features of Elements Liv A Gain
Elements Liv A Gain stands out due to its unique blend of natural ingredients specifically designed to support liver health. Its powerful antioxidant & anti-inflammatory properties help in maintaining a healthy liver function. This supplement combines traditional herbs with modern science, offering a comprehensive approach to liver care.
Effectiveness Compared to Other Products
When compared to other liver supplements, Elements Liv A Gain shows promising results. Users have reported improved liver function and overall well-being. The supplement’s ability to support healthy liver function and strong immunity means a better life for many users. Its effectiveness is backed by scientific research, making it a reliable choice for those seeking liver health support.
Cost-Benefit Analysis
In terms of cost, Elements Liv A Gain offers good value for money. While it may be priced slightly higher than some other supplements, the benefits it provides justify the cost. Users find that the investment in their liver health pays off with better overall health and vitality. Here’s a quick comparison:
| Supplement | Price | Key Benefits |
|---|---|---|
| Elements Liv A Gain | $$ | Comprehensive liver support, antioxidant & anti-inflammatory properties |
| Other Supplement A | $ | Basic liver support |
| Other Supplement B | $$ | Antioxidant properties |
Investing in a quality liver supplement like Elements Liv A Gain can lead to long-term health benefits, making it a worthwhile choice for those serious about their liver health.
Incorporating Elements Liv A Gain into Your Daily Routine
Recommended Dosage and Usage
To get the best results from Elements Liv A Gain, it’s important to follow the recommended dosage. Typically, users are advised to take one capsule daily with a meal. Always consult with a healthcare provider before starting any new supplement to ensure it fits your health needs.
Best Practices for Maximum Benefits
For maximum benefits, take the supplement at the same time each day. This helps your body get used to the routine. Drinking plenty of water and maintaining a balanced diet can also enhance the effects of Elements Liv A Gain. Here are some tips:
- Take with a meal for better absorption.
- Stay hydrated throughout the day.
- Combine with a healthy diet rich in fruits and vegetables.
Potential Side Effects and Precautions
While Elements Liv A Gain is generally safe, some people might experience mild side effects like stomach upset. If you notice any unusual symptoms, stop taking the supplement and consult your doctor. It’s also important to avoid taking more than the recommended dose to prevent any adverse effects.
Elements Liv A Gain contains a combination of vitamins, minerals, and herbal extracts. Together, these components maintain general liver health and support detoxification processes.
Holistic Approaches to Liver Health
Dietary Recommendations
Eating the right foods can make a big difference in liver health. Fresh fruits and vegetables are packed with nutrients that support liver function. Whole grains, lean proteins, and healthy fats are also important. Avoiding processed foods, sugary drinks, and excessive alcohol can help keep your liver in top shape.
Lifestyle Changes
Simple lifestyle changes can have a huge impact on liver health. Regular exercise helps maintain a healthy weight, which is crucial for liver function. Getting enough sleep and managing stress are also important. Staying hydrated by drinking plenty of water helps the liver flush out toxins.
Complementary Therapies
Complementary therapies like acupuncture, massage, and herbal supplements can support liver health. These therapies can help reduce stress and improve overall well-being. Always consult with a healthcare provider before starting any new therapy to ensure it’s safe and effective for you.
Taking a holistic approach to liver health means looking at the whole picture, including diet, lifestyle, and complementary therapies. This comprehensive strategy can lead to better liver function and overall health.
Where to Buy Elements Liv A Gain
Authorized Retailers
To ensure you’re getting the genuine product, it’s best to purchase Elements Liv A Gain from authorized retailers. These stores have been verified to sell authentic supplements, so you can trust the quality and safety of what you’re buying.
Online Purchasing Options
Buying Elements Liv A Gain online is convenient and often offers more variety. Look for reputable websites that have good customer reviews and clear return policies. Some popular online stores include:
- Official brand website
- Major e-commerce platforms like Amazon
- Health and wellness specialty sites
Tips for Avoiding Counterfeits
Counterfeit products can be harmful and ineffective. To avoid them, always check for a seal of authenticity on the packaging. Additionally, be wary of prices that seem too good to be true, as they often indicate fake products. If in doubt, contact customer service for verification.
Always prioritize your health by ensuring the supplements you buy are genuine and safe.
Looking to buy Elements Liv A Gain? Visit our website for the best deals and a wide selection of products. Don’t miss out on our special offers!
Conclusion
In conclusion, Elements Liv A Gain offers a range of benefits for liver health. By supporting liver function, it helps in detoxifying the body, improving digestion, and boosting overall energy levels. With its natural ingredients, it provides a safe and effective way to maintain a healthy liver. Whether you are looking to improve your liver health or maintain it, Elements Liv A Gain is a valuable addition to your wellness routine. Remember, a healthy liver is key to a healthy life.
Frequently Asked Questions
What are the main ingredients in Elements Liv A Gain?
Elements Liv A Gain contains natural ingredients like milk thistle, turmeric, and dandelion root which are known for supporting liver health.
How does Elements Liv A Gain help my liver?
This supplement helps by providing antioxidants and nutrients that support liver function and aid in detoxification.
Can I take Elements Liv A Gain every day?
Yes, you can take it daily. Just follow the recommended dosage on the label or ask your doctor.
Are there any side effects of using Elements Liv A Gain?
Most people do not experience side effects, but some might have mild digestive issues. It’s best to start with a small dose.
How long does it take to see results from Elements Liv A Gain?
Results can vary, but many users notice a difference in their energy levels and digestion within a few weeks.
Where can I buy Elements Liv A Gain?
You can buy it from authorized retailers or online. Be sure to purchase from trusted sources to avoid counterfeits.